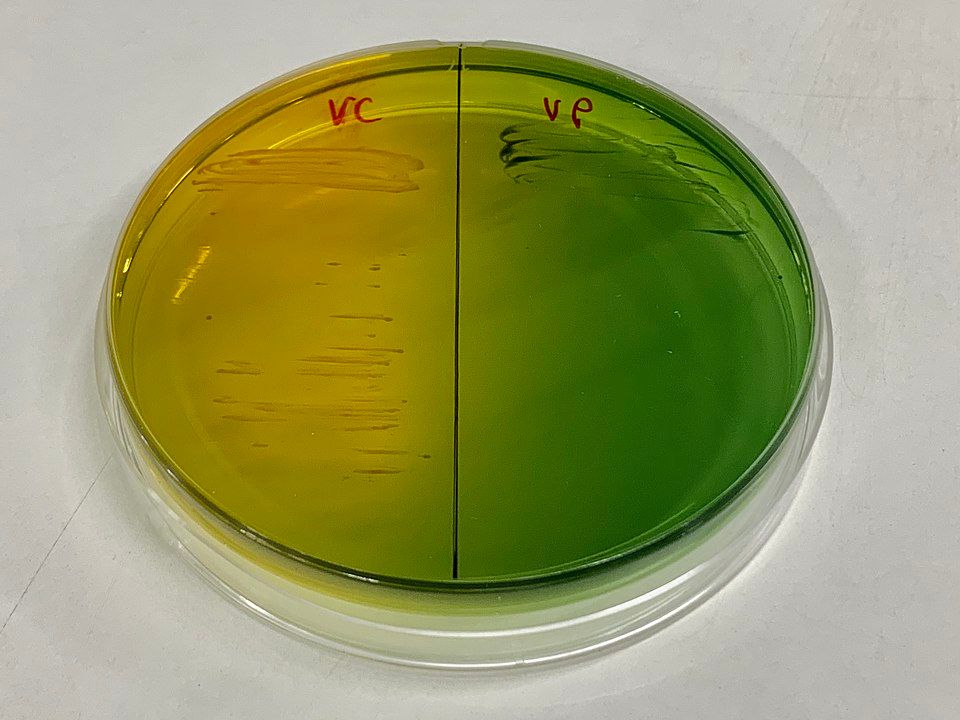
การเลี้ยงเชื้อ Vibrio cholerae และ Vibrio parahaemolyticusในจานเพาะเชื้อ

Vibriosis หรือโรคติดเชื้อแบคทีเรียวิบริโอ สามารถพบได้บ่อยในประเทศที่มีสภาพอากาศร้อนชื้น มีสาเหตุจากแบคทีเรียในสกุล Vibrio ซึ่งเป็นจุลชีพที่อาศัยอยู่ตามระบบนิเวศน้ำเค็มและน้ำกร่อยในอุณหภูมิค่อนข้างอุ่น เชื้อในกลุ่มนี้มีหลายชนิด แต่ที่มีความสำคัญทางการแพทย์มากที่สุด ได้แก่ Vibrio parahaemolyticus, V. vulnificus และ V. cholerae (ยกเว้นสายพันธุ์ก่ออหิวาตกโรค) แต่ละชนิดก่อให้เกิดอาการและความรุนแรงที่แตกต่างกัน ตั้งแต่ท้องเสียเล็กน้อยหลังรับประทานอาหารทะเลดิบ ไปจนถึงการติดเชื้อในกระแสเลือดแบบเฉียบพลัน ซึ่งอาจเป็นอันตรายถึงชีวิตภายในเวลาไม่กี่ชั่วโมงได้

ในธรรมชาติ เชื้อวิบริโอเป็นส่วนหนึ่งของระบบนิเวศทางทะเล (Marine Microbiota) เจริญเติบโตได้ดีในสภาพแวดล้อมที่มีความเค็มและอุณหภูมิสูงกว่า 25–30°C เมื่ออุณหภูมิน้ำทะเลอุ่นขึ้น จำนวนเชื้อวิบริโอในน้ำจะเพิ่มขึ้นหลายเท่า ทำให้ช่วงฤดูร้อนเป็นช่วงที่พบโรคนี้บ่อยที่สุด การรับเชื้อเข้าสู่ร่างกายมักเกิดจากการกินอาหารทะเลดิบหรือสุกไม่ทั่วถึง เช่น หอยนางรมสด ปลาหรือกุ้งที่ผ่านการหมัก ดอง หรือทำแบบกึ่งสุกกึ่งดิบ ในหลายกรณี เชื้อยังสามารถเข้าสู่ร่างกายผ่านทางบาดแผลที่สัมผัสน้ำทะเลที่ปนเปื้อน โดยเฉพาะในผู้ที่มีโรคประจำตัว เช่น โรคตับ ผู้ดื่มแอลกอฮอล์เป็นประจำ หรือผู้มีภูมิคุ้มกันบกพร่อง ซึ่งเป็นกลุ่มที่มีความเสี่ยงต่อความรุนแรงของโรคสูงกว่า
แม้เชื้อ V. parahaemolyticus จะก่อให้เกิดโรคในระบบทางเดินอาหารเป็นหลัก เช่น อาการท้องเสียเฉียบพลัน ปวดท้อง คลื่นไส้ และไข้ต่ำ แต่โรคจากเชื้อ V. vulnificus ถือว่ามีความร้ายแรงสูงเป็นพิเศษ เนื่องจากเชื้อนี้สามารถเจริญและแพร่กระจายได้เร็ว ทำลายเนื้อเยื่ออย่างเฉียบพลัน พบได้ทั้งจากการกินอาหารทะเลดิบและการสัมผัสบาดแผลกับน้ำทะเลปนเปื้อน โดยทั้งสองเส้นทางสามารถก่อโรครุนแรงได้ เมื่อเชื้อเข้าสู่แผล แม้จะเป็นบาดแผลขนาดเล็กมาก เช่น แผลถลอกหรือถูกเปลือกหอยบาด ก็สามารถทำให้เกิดการติดเชื้อผิวหนังแบบลุกลาม (Necrotizing Soft Tissue Infection) ผิวหนังอาจบวมแดง เจ็บรุนแรง มีตุ่มน้ำหรือเลือดคั่ง และลุกลามภายในเวลาไม่กี่ชั่วโมง ในรายที่เชื้อเข้าสู่กระแสเลือด อาจเกิดภาวะติดเชื้อในกระแสเลือดเฉียบพลัน (Septicemia) ซึ่งมีอัตราการเสียชีวิตสูงมากหากไม่ได้รับการรักษาภายในเวลาอันสั้น

การวินิจฉัย Vibriosis ไม่ได้พิจารณาจากอาการเพียงอย่างเดียว แต่ต้องประเมินร่วมกับประวัติการสัมผัส เช่น การรับประทานอาหารทะเลดิบในช่วงก่อนเกิดอาการ หรือมีแผลแล้วลงเล่นน้ำทะเลในช่วงฤดูร้อน การตรวจทางห้องปฏิบัติการเป็นอีกหนึ่งวิธีการวินิจฉัยปัจจัย โดยเฉพาะการเพาะเชื้อจากอุจจาระ เลือด หรือสารคัดหลั่งจากแผล เพื่อระบุชนิดของแบคทีเรียและประเมินความไวต่อยาปฏิชีวนะ (Antibiotic Susceptibility) ในโรงพยาบาลที่มีความพร้อม อาจใช้วิธีการตรวจแบบ PCR เพื่อเพิ่มความรวดเร็วในการยืนยันเชื้อ ซึ่งมีประโยชน์อย่างยิ่งในผู้ป่วยที่มีอาการรุนแรง เนื่องจากการให้ยาปฏิชีวนะเร็วที่สุดเป็นปัจจัยสำคัญในการลดอัตราการเสียชีวิต
การรักษาโรค Vibriosis แบ่งออกตามระดับความรุนแรงของอาการ ผู้ป่วยส่วนใหญ่ที่ติดเชื้อ V. parahaemolyticus จะมีอาการเพียงเล็กน้อยและหายได้เองภายในไม่กี่วัน การรักษาหลักคือการให้สารน้ำเพื่อลดภาวะขาดน้ำจากการท้องเสีย แต่ในกลุ่มผู้ป่วยที่มีอาการรุนแรงหรือมีโรคประจำตัว แพทย์จะพิจารณาให้ยาปฏิชีวนะ เช่น Doxycycline, Ciprofloxacin หรือยากลุ่ม Fluoroquinolones อื่น ๆ หากสงสัย V. vulnificus ซึ่งมีความรุนแรงสูง การรักษาจะต้องเริ่มทันทีด้วยยาต้านแบคทีเรียชนิดผสม เช่น Ceftazidime ร่วมกับ Doxycycline หรือทางเลือกอื่นตามแนวทางการรักษาโรคติดเชื้อไม่ทราบสาเหตุ โดยไม่รอผลเพาะเชื้อ เนื่องจากการเริ่มการรักษาล่าช้าเพียงไม่กี่ชั่วโมงอาจเพิ่มความเสี่ยงต่อภาวะช็อกและเสียชีวิตได้
ในกรณีติดเชื้อผ่านบาดแผล หากพบอาการบวมแดงลุกลามหรือสงสัยเนื้อเยื่อตาย แพทย์อาจต้องทำการผ่าตัดเอาเนื้อเยื่อที่ติดเชื้อออก (Surgical Debridement) เพื่อหยุดการลุกลามของเชื้อ บางรายที่มีการติดเชื้ออย่างรุนแรง อาจต้องตัดอวัยวะบางส่วนเพื่อช่วยชีวิต นอกจากนี้ผู้ป่วยที่มีภาวะติดเชื้อในกระแสเลือดจะต้องเข้ารับการรักษาในหอผู้ป่วยวิกฤต (ICU) เพื่อดูแลการทำงานของอวัยวะต่าง ๆ มีการให้สารน้ำ ยากระตุ้นความดันโลหิต (Vasopressors) และยาปฏิชีวนะขนาดสูงในทันที
แม้โรค Vibriosis จะสามารถป้องกันได้ง่าย แต่ความประมาทในการบริโภคอาหารทะเลดิบเป็นสาเหตุหลักที่ทำให้เกิดโรคมากที่สุด โดยเฉพาะในผู้ที่ชื่นชอบหอยนางรมดิบซึ่งมีความเสี่ยงสูงเป็นพิเศษ เนื่องจากหอยนางรมเป็นสัตว์กรองกิน (Filter Feeder) ที่สามารถสะสมเชื้อในตัวเองได้หลายเท่าของน้ำทะเลรอบ ๆ ตัวมัน ดังนั้นการปรุงอาหารทะเลให้สุกทั่วถึงจึงเป็นวิธีป้องกันที่สำคัญที่สุด นอกจากนี้ ผู้ที่มีบาดแผลควรหลีกเลี่ยงการลงเล่นน้ำทะเล และผู้มีโรคตับเรื้อรังควรงดเว้นการรับประทานอาหารทะเลดิบโดยเด็ดขาด เนื่องจากเป็นกลุ่มที่มีอัตราการเสียชีวิตจาก V. vulnificus สูงที่สุด

ในภาพรวม Vibriosis แม้จะไม่ใช่โรคระบาดใหญ่ แต่เป็นโรคที่มีความเสี่ยงสูงสำหรับบางกลุ่มประชากร ความเข้าใจผิดเกี่ยวกับความปลอดภัยของอาหารทะเลดิบเป็นปัจจัยที่ทำให้โรคยังคงพบได้บ่อย โดยเฉพาะในช่วงฤดูร้อนที่เชื้อเพิ่มจำนวนในธรรมชาติมากกว่าปกติ การตระหนักรู้ถึงสาเหตุ กลไกการติดเชื้อ อาการที่ควรระวัง และแนวทางการรักษา จึงเป็นสิ่งสำคัญที่ช่วยลดความรุนแรงของโรคได้
เรียบเรียงโดย
โชติทิวัตถ์ จิตต์ประสงค์
ภาควิชาศัลยศาสตร์ออร์โธปิดิกส์และการบาดเจ็บ
คณะแพทยศาสตร์ มหาวิทยาลัย The Chinese University of Hong Kong.
อัปเดตข้อมูลแวดวงวิทยาศาสตร์ เทคโนโลยี รู้ทันโลกไอที และโซเชียลฯ ในรูปแบบ Audio จาก AI เสียงผู้ประกาศของไทยพีบีเอส ได้ที่ Thai PBS
“รอบรู้ ดูกระแส ก้าวทันโลก” ไปกับ Thai PBS Sci & Tech









